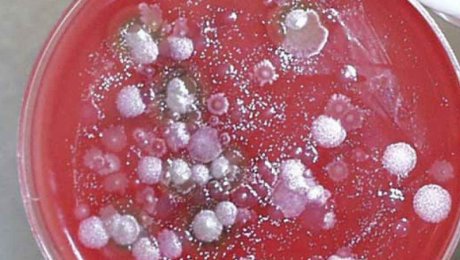
Главный ветеринарный-санитарный врач области: В Прииртышье сибирская язва не выявлена Главный ветеринарный-санитарный врач области: В Прииртышье сибирская язва не выявлена

Ежедневные Архивы: 09.07.2016
                        "В Иртышском районе сибирской язвы нет", – заявил на специальном брифинге главный государственный ветеринарный санитарный инспектор Павлодарской области Рашид Нурбеков. Результаты проведенных исследований показали: мясо коровы чистое, характерных сибирской язве симптомов нет.  "Несмотря на отрицательные результаты, мы пригласили эксперта из Национального референтного центра ветеринарии, который также отобрал материалы....                    
                    
                
                        Двух жителей села Узынсу Иртышского района Павлодарской области госпитализировали в инфекционную больницу с подозрением на сибирскую язву, передает Bnews.kz.  По информации областного управления здавоохранения, сельчане обнаружили у у себя гнойники после забоя коровы. После этого они обратились за медицинской помощью. В настоящее время жители села находятся в областной...                    
                    
                
                        Число контактировавших с потенциально зараженным сибирской язвой животным возросло до 25 человек, сообщает корреспондент Today.kz со ссылкой на руководителя управления здравоохранения Нурлана Касимова.  По словам главного врача Павлодарской области, у них пока не наблюдается никаких признаков заражения.  Глава облздрава отметил, что контактировавшие с потенциально зараженным сибирской язвой...                    
                    
                
                        В Алматы неоднократно судимый мужчина совершил убийство 6-летней девочки. Об этом сообщила официальный представитель ДВД города Салтанат Азирбек, передает Казинформ.  По ее данным, 7 июля в 22.00 мама девочки обратились в полицию, сообщив об исчезновении своего ребенка. В 22.50 были организованы первоначальные поисковые мероприятия участковыми инспекторами. В результате...                    
                    
                
                        Анализы двух жителей Павлодарской области с подозрением на сибирскую язву показали - диагноз болезни не подтвердился, передает BNews.kz.  Об этом заявил Главный государственный ветеринарный-санитарный врач области Рашид Нурбеков.  По его словам, в селе Узынсу не объявлен карантин, так как не выявлена сибирская язва.  «Забитый скот с...                    
                    
                
                        "Поезд Актау-Актобе 8 июля стоял в степи 6 часов. В вагонах жара. Все люди с детьми. И 6 часов сидели на рельсах рядом с поездом. С Актау выехали и через 4 часа встали", – пишет zello.aktobe в Instagram. В пресс-службе "Қазақстан темір жолы" сообщают, что 8 июля пассажирский поезд №309 сообщением Актобе-Актау прибыл...                    
                    
                
                        Руководитель управления здравоохранения Павлодарской области Нурлан Касимов подтвердил информацию о госпитализации двух жителей Иртышского района. 8 июля сельчан перевезли санитарной авиацией в областную инфекционную больницу. Под карантином находится 51-летний мужчина и 31-летняя женщина. Оба принимали участие в забое и разделке коровы. Их состояние оценивается как средней степени тяжести. ...                    
                    
                
                        В Организации по безопасности и сотрудничеству в Европе поздравили Казахстан с избранием в состав непостоянных членов Совета Безопасности Организации Объединенных Наций, передает News2.kz со ссылкой на пресс-службу МИД РК. 7 июля постоянный представитель РК при международных организациях в Вене посол Кайрат Сарыбай в ходе заседания постоянного совета ОБСЕ выступил с заявлением об...                    
                    
                
                        В Иргизском районе Актюбинской области назначили нового акима, передает Казинформ.  Как сообщили в акимате региона, распоряжением акима Актюбинской области Бердыбека Сапарбаева в соответствии с законодательством, с согласия администрации Президента, районного маслихата, акимом Иргизского района назначен Мади Елеусизов.  До нового назначения 40-летний М.Елеусизов занимал должность руководителя аппарата акима...                    
                    
                Погода в Астане
Нур-Султан
			небольшой снег
			
		
					-10
					°
					C
				
				
						
						-10
						°
					
					
						
						-10
						°
					
				
					
					85						%
				
				
					
					6kmh
				
				
					
					100						%
				
			Вт
						
							-8
							°
						
					Ср
						
							-7
							°
						
					Чт
						
							-2
							°
						
					Пт
						
							1
							°
						
					Сб
						
							0
							°